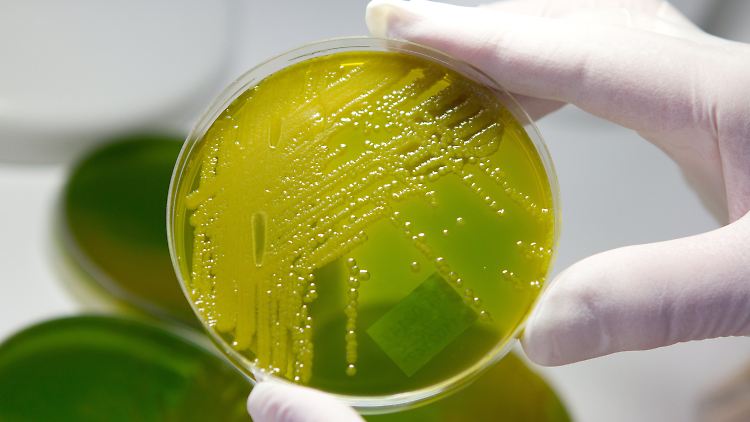

EHEC-Gurken auch in Tschechien Aigner: Warnung bleibt bestehen
29.05.2011, 08:33 Uhr
EHEC-Keime auf einem Nährboden.
(Foto: dpa)
Vier Buchstaben verbreiten Unruhe. Die EHEC-Welle hat bisher zehn Todesopfer gefordert. Und der Höhepunkt ist wohl noch nicht erreicht. Bundesministerin Aigner hält an der Warnung vor dem Verzehr für rohe Gurken, Blattsalate und Tomaten fest. Nun vermeldet auch Tschechien, dass kontaminierte Gurken in den Handel gelangt sind.
Bundesverbraucherschutzministerin Ilse Aigner (CSU) hält wegen der anhaltenden Erkrankungswelle durch den Darmkeim EHEC an der Warnung vor dem Verzehr für rohe Gurken, Blattsalate und ungekochte Tomaten fest. Aigner sagte "Bild am Sonntag": "Solange es den Experten in Deutschland und Spanien nicht gelungen ist, die Quelle des Erregers zweifelsfrei zu benennen, haben die allgemeinen Warnhinweise für Gemüse weiterhin Bestand."
Der Höhepunkt der EHEC-Welle ist offenbar noch nicht erreicht. Die Zahl der Krankheits- und Verdachtsfälle steigt. Wo die Ursache liegt, ist weiter unklar. Bis zum Samstag sind dem gefährlichen Darmkeim zehn Menschen zum Opfer gefallen. Mehr als die Hälfte der Bundesbürger verzichtet als Konsequenz auf viele Gemüsesorten. Betroffene Bauern beklagen Riesenschäden. Deutsche Erzeugerverbände meldeten unterdessen nach Labortests ihre Ware "EHEC-frei".
Deutschlandweit wurden mittlerweile mehr als 1000 bestätigte und EHEC-Verdachtsfälle registriert. Normalerweise gibt es im ganzen Jahr etwa 900 gemeldete Infektionen mit den Bakterien. Von den zehn Toten waren neun Opfer Frauen. Bislang stammen alle Todesopfer aus Norddeutschland. Bundesweit schweben mehrere Menschen in Lebensgefahr.
Neue HUS-Behandlung
Allein in Niedersachsen wurden bis Samstag 141 bestätigte Erkrankungen, 48 EHEC-Verdachtsfälle und 42 HUS-Fälle registriert. HUS steht für hämolytisch-urämisches Syndrom. "Wir müssen davon ausgehen, dass die Zahl der Schwererkrankten noch weiter steigt", sagte der Sprecher des Sozialministeriums. Wegen Überlastungen verlegen Hamburger Kliniken Erkrankte derzeit nach Niedersachsen. In Hamburg liegt die Zahl bei etwa 400 Patienten.

Im Universitätsklinikum Hamburg-Eppendorf setzt man auf eine neue Behandlungsmethode gegen HUS.
(Foto: picture alliance / dpa)
Es handelt sich nach Angaben des Europäischen Zentrums für Krankheitskontrolle und Prävention in Stockholm (EDCD) nicht nur um einen der größten Ausbrüche der Krankheit weltweit, sondern auch um den größten jemals in Deutschland. In einem Gutachten heißt es, dass "die Quelle der Infektionen noch aktiv ist", da die Zahl der Erkrankten weiter steige. Überdies seien die Vorfälle außergewöhnlich, da hauptsächlich Erwachsene an HUS erkrankten. "Gewöhnlich wird HUS bei Kindern unter fünf Jahren festgestellt. Dieses Mal sind 87 Prozent der Betroffenen Erwachsene und hauptsächlich Frauen (68 Prozent)".
Mediziner setzen gegen HUS inzwischen auf eine neue Behandlung. So bekommen in der Hamburger Uniklinik Eppendorf (UKE) sechs EHEC-Infizierte mit Komplikationen den Antikörper Eculizumab, wie UKE-Professor Rolf Stahl berichtete. Ärzte und Wissenschaftler aus Heidelberg, Montreal und Paris stellten im Fachblatt "New England Journal of Medicine" die erfolgreiche Behandlung von drei Kleinkindern mit diesem Antikörper vor. Die Kinder waren im vergangenen Jahr nach EHEC-Infektionen an HUS erkrankt.
Nun auch Tschechien betroffen
Auch in Tschechien sind mit dem Darmkeim kontaminierte Gurken in den Handel gelangt. Noch wisse man aber nicht, ob die gesundheitsschädliche Ware auch bereits an Endverbraucher verkauft worden sei, teilte die tschechische Lebensmittelinspektion SZPI nach einem Bericht der Nachrichtenagentur CTK mit. Dies könne erst durch Überprüfungen im Laufe des Sonntags festgestellt werden.
Nach den Worten von SZPI-Sprecher Michal Spacil sei eine Sendung von Bio-Salatgurken aus Spanien betroffen, die "im Laufe der vergangenen Tage" nach Tschechien geliefert worden sei. Die Information darüber habe die tschechische Behörde zunächst über das Frühwarnsystem der Europäischen Union erhalten und sofort ein Verkaufsverbot für die bedenkliche Ware erlassen.
Quelle: ntv.de, dpa/rts